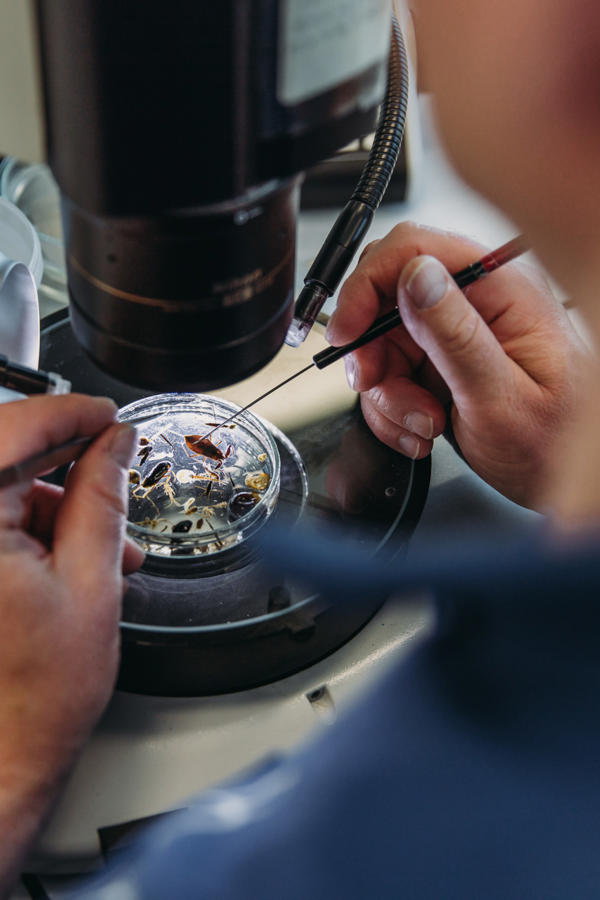

Onze mensen verdienen het beste
Goed voor onze mensen zorgen staat hoog in het vaandel bij AQUON. We bieden je uitstekende arbeidsvoorwaarden en je werkt in een hypermodern kantoorpand.
€49251 - €64381
Je jaarsalaris
32
Aantal uur per week
AQUON Houten
Je werklocatie
Waterschap
CAO
Wat ga je doen als Hydrobioloog?
Ben jij de proactief, resultaatgericht en heb je passie voor alles wat leeft in en om het water? Ben jij in staat om een uitstekend beeld te geven van de ecologische waterkwaliteit. Binnen het team Hydrobiologie zit jij dan helemaal op je plek!
Wat ga je doen?
Als Hydrobioloog ben jij verantwoordelijk voor het geven van integraal inzicht en advies aan waterschappen als basis voor het waterbeheer en rapportage aan de samenleving over de waterkwaliteit. Jij doet veldwerk, analyseert, rapporteert en geeft advies. Jij bent samen met de collega’s uit het team altijd op zoek naar hoe het werk beter en slimmer kan en je neemt initiatief. Jij vormt een schakel tussen het veld en de informatie over waterkwaliteit voor onze 9 waterschappen.

Wat vragen we van jou?
Wat bieden we jou?
Wij bieden jou...
- Een trotse, innovatieve en kwaliteit gedreven organisatie waar de communicatielijnen kort en direct zijn en wij vol passie bezig zijn met ons vak.
- Een klantgerichte organisatie waarbinnen jij met je collega’s, ieder vanuit zijn of haar specialisme, enorm belangrijk werk doet. Namelijk werken aan de waterkwaliteit van Nederland.
- Flexibele arbeidsvoorwaarden, zoals:
- 21% IKB (Individueel Keuze Budget), dit kun je onder andere inzetten voor vakantietoeslag, eindejaarsuitkering of het kopen van extra vakantiedagen.
- 6.000 euro per 5 jaar aan Persoonsgebonden Basis Budget, waarmee persoonlijke ontwikkelings- en opleidingsmogelijkheden gefinancierd kunnen worden.
- De functie van Hydrobioloog is ingeschaald in schaal 8 van de CAO Werken voor Waterschappen. Afhankelijk van je ervaring wordt het salaris bepaald, met een bruto maandsalaris tussen de €3392,- en €4434,- voor 36 uur per week (maximumjaarsalaris van €64.381,- inclusief 21% individueel keuzebudget).
- Een reiskostenvergoeding.
- Een goede pensioenvoorziening bij het ABP.

In dit team ga je werken
Je komt te werken in het team Hydrobiologie. Al het leven in en om het water is onze passie. Het team biedt via adviezen en rapportages inzicht in de biodiversiteit, soorten/exoten en waterkwaliteit. De basis van dat inzicht komt uit veldkennis, monstername, soortenkennis, eDNA analyses, kennis van het watersysteem en voedselweb. De samenwerking met team Chemie, team Monstername & Logistiek en de ecologen van de waterschappen verzekert ook een integraal inzicht in de waterkwaliteit. Dit ondersteunt de waterschappen bij het inrichten en beheren van het watersysteem.

Onze manager Hydrobiologie Hans Massop

Annemieke de Bot, jouw contactpersoon


Solliciteer op deze vacature
Leuk dat je interesse hebt. Wij ontvangen graag je sollicitatie! Je kan je interesse en sollicitatie via onze website kenbaar maken. Wij kijken uit naar jouw bericht en nemen zo spoedig mogelijk contact met je op.